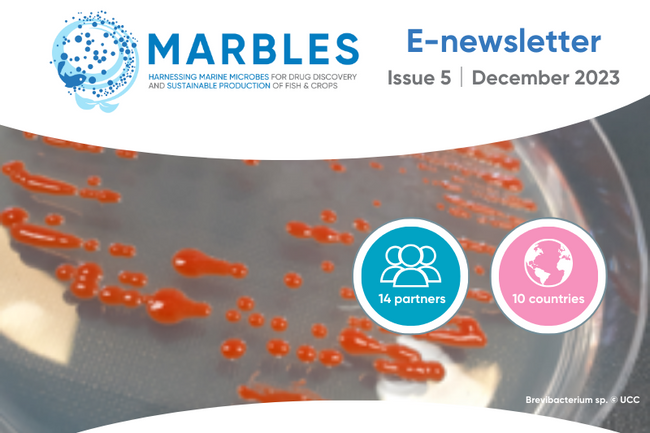
image-63635c6c31b3e0b99ac33caaef28095618c85b7d-800x600-png

News
Filter News by:
news

Marine fungi a promising source of novel bioactive natural products
04 Mar 2024
Novel natural product compounds are becoming more and more necessary to treat the rising number of drug-resistant viruses, bacteria, and cancers. Due to their distinct secondary metabolic pathways along with their substantial biodiversity, marine fungi are now a major source of natural products for use in drug development research.
news

Under the Naturalis Spotlight: How can a sponge heal us?
20 Feb 2024
MARBLES partner Naturalis Biodiversity Center hold Spotlight sessions so their experts can share the latest knowledge, demonstrate museum collection pieces and talk passionately about their work within the museum. MARBLES researcher Niels van der Windt Spotlight session was entitled: How can a sponge heal us?
news

Advanced technology aids efforts to research fragile deep sea animals
12 Feb 2024
In order to accelerate the search for new life in the deep sea, a collaborative group of roboticists, ocean engineers, bioengineers, and marine and molecular biologists has successfully proven how new technologies can efficiently collect high-resolution 3D images and preserved tissue of deep sea animals.
news

DNA from the ocean’s ‘Twilight Zone’ could lead to new lifesaving drugs
22 Jan 2024
More than 300 million groups of marine bacteria, viruses and fungi have had their genes recorded by researchers into the largest-ever database of marine microbes, the KMAP Global Ocean Gene Catalog 1.0. This is in the hopes that the database will lead to innovations in the fields of agriculture, energy, and medicine.
news

Temperature variation influences the gut and skin microbiomes of chum salmon
03 Jan 2024
The study implies the exposure of chum salmon to temperature fluctuations triggers dysbiosis in their microbiomes.
news

NAICONS launches the MICRO4ALL Platform
18 Dec 2023
MARBLES partner NAICONS (Italy) has set up the MICRO4ALL Platform, a vast online database of naturally occurring molecules that are both known and yet to be identified.
news

Scottish salmon farms see antibiotic use halved
05 Dec 2023
A new report published by the UK Government has highlighted that since the Covid-19 pandemic, the use of antibiotic medication by Scotland's salmon farming companies has decreased by more than half.
news
MARBLES E-Newsletter Issue 5 - Out now!
01 Dec 2023
All the latest news, events and highlights from the project, including how probiotics are being used to improve fish health, our contributions to the High Seas Treaty negotiations, meet MARBLES researcher Victor Carrion Bravo in the Netherlands and learn how microbes protect whale sharks!
news

MARBLES partner DTU visit Stolt Sea Farm to see probiotics in action
13 Nov 2023
For over 20 years, Stolt Sea Farm has been working closely with MARBLES partner the Technical University of Denmark (DTU) to study the use of probiotics in aquaculture.
news

Microbial communities and mineral assemblages in sediments at cold seeps
06 Nov 2023
At the Haima cold seep, Liang et al. studied the mineral assemblages and microbial communities at various habitats and their relationships to environmental factors.
news

Vineyards of the future will produce more than wine
04 Nov 2023
Europe is attempting to use winemaking emissions and residues to create new products ranging from animal feed to antibiotic alternatives.
news

MARBLES researchers planning for Marine Natural Products GRC 2024
02 Nov 2023
The conference with the theme 'From Discovery to Production via Function to Applications' will take place in California from 10-15 March 2024.